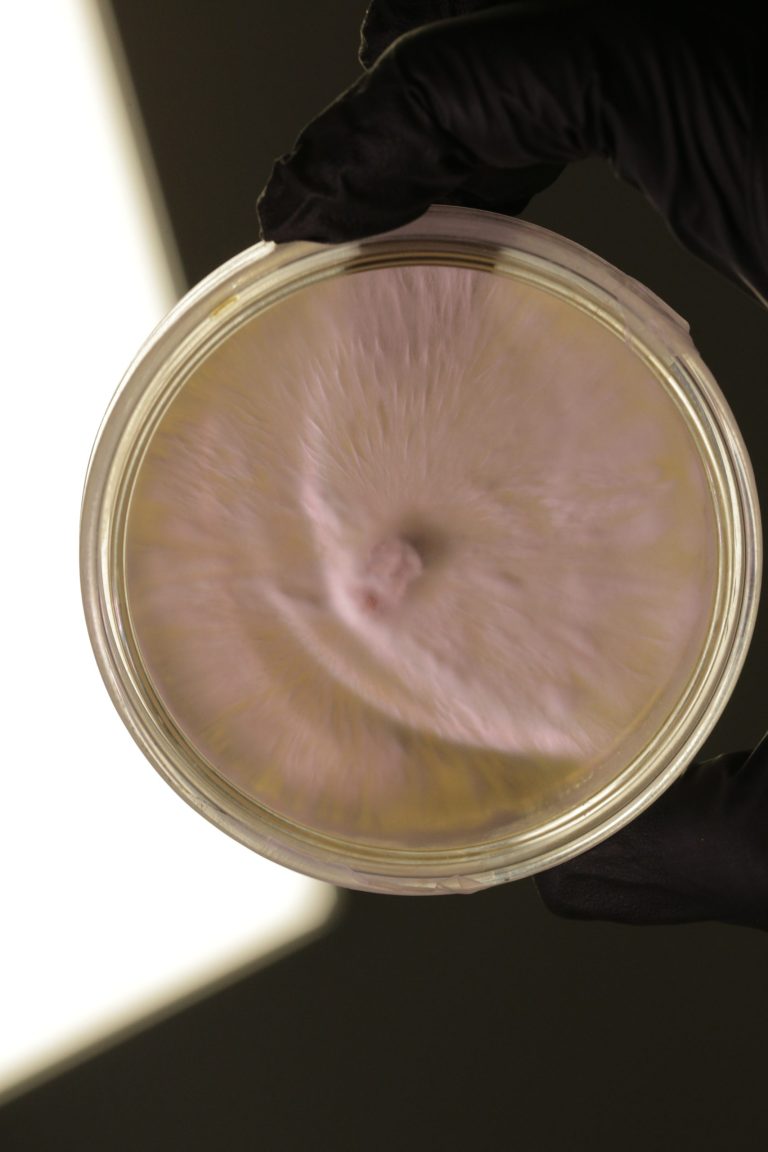
Sara.Scanderebech
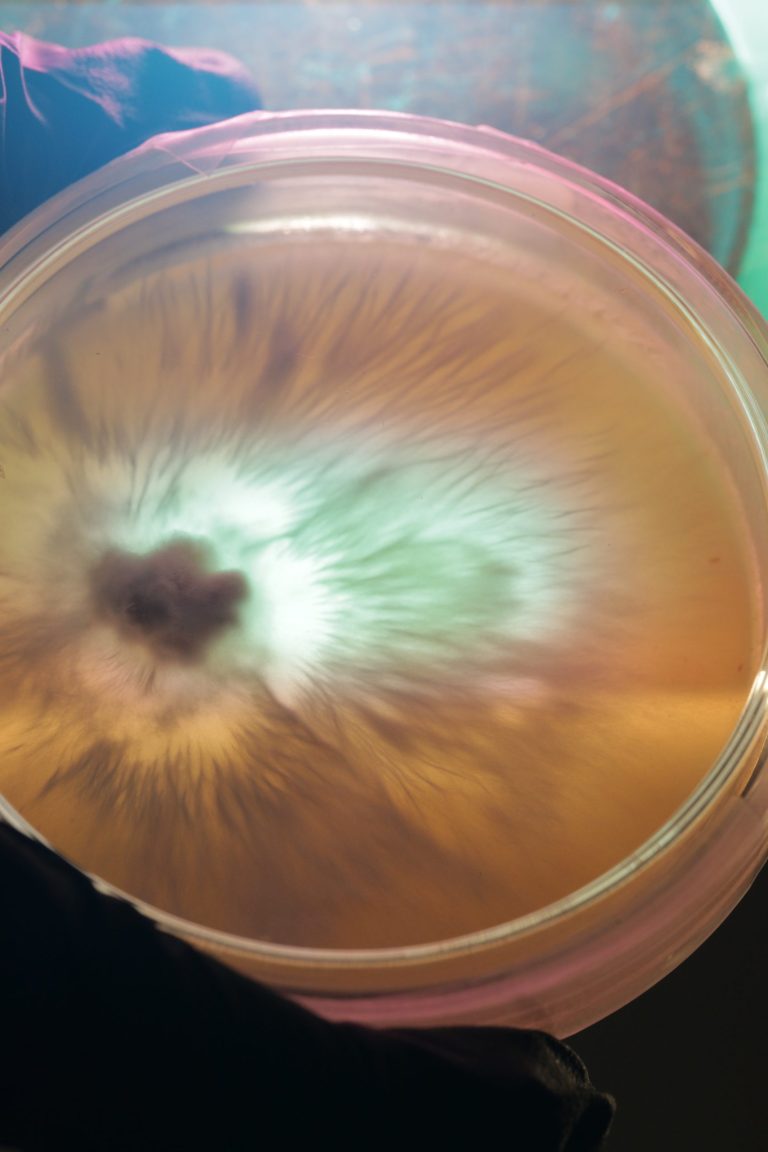
Sara.Scanderebech

Funghi freschi premium
Prodotti, raccolti e consegnati dalla città.
LOCALE
Le città come oasi di cibo.
La nostra filosofia si radica sulla produzione alimentare a corto raggio, valorizzando le particolari risorse e caratteristiche spaziali dell’ambiente urbano.
SALUTARE
Il cibo come medicina.
Riconnettiamo la coltivazione di cibo al benessere fisico e mentale.
Con i funghi, ci focalizziamo su pratiche sane e prodotti ricchi di macro e micronutrienti.
RESPONSABILE
La funga come soluzione.
Rivendichiamo una filiera innovativa e future-proofed, fondata sui principi dell’economia circolare, della preservazione ambientale e lo sviluppo di sistemi agroalimentari durabili.